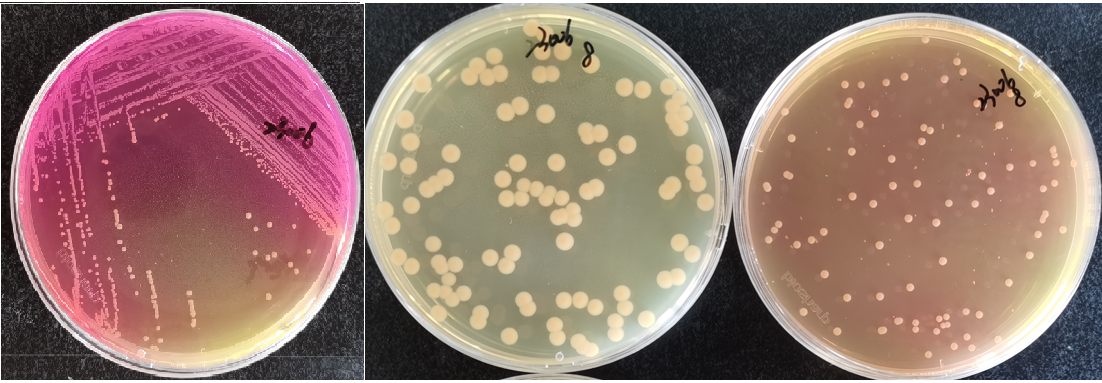
制藥行業(yè)中的隱形殺手-洋蔥伯克霍爾德菌群 制藥行業(yè)中的隱形殺手-洋蔥伯克霍爾德菌群

洋蔥伯克霍爾德菌群容易存活在水系統(tǒng)以及液體產(chǎn)品中,且能在有強抑菌性的產(chǎn)品中生長繁殖�����,可能增加用藥人群感染和致病風(fēng)險�����,目前美國藥典將其列為吸入劑、水溶性口服制劑等制劑中不可檢出的微生物���,如果產(chǎn)品中檢出該微生物�����,可直接將其作為不可接受微生物。
接下來我們分別介紹一下“不可接受微生物”和“洋蔥伯克霍爾德菌群”�。
一�、不可接受微生物
《中國藥典》(2020版)1107中明確規(guī)定了:“本限度標準所列的控制菌對于控制某些藥品的微生物質(zhì)量可能并不全面,因此�,對于原料��、輔料及某些特定的制劑,根據(jù)原輔料及其制劑的特性和用途�、制劑的生產(chǎn)工藝等因素,可能還需檢查其他具有潛在危害的微生物�?!盪SP和EP中也提到“For a given preparation it may be necessary to test for other?microorganisms depending on the nature of the starting materials?and the manufacturing process.”
在非無菌藥品的微生物控制中,其他具有潛在危害的微生物也需要加以關(guān)注�����,這些微生物也有可能在微生物計數(shù)或某項控制菌檢驗過程中被發(fā)現(xiàn)�?����!吨袊幍洹泛兔绹穆?lián)邦法規(guī)21CFR均提到了非藥典規(guī)定的控制菌,其中有致病菌或條件致病菌����,如果非無菌藥品中存在足夠的數(shù)量,通過用藥途徑可能對患者的健康產(chǎn)生不可接受的風(fēng)險����,則這類微生物叫做不可接受微生物(Objectionable microorganisms)�。
而正是洋蔥伯克霍爾德菌的出現(xiàn)促使了“不可接受微生物”概念的誕生��。
二、洋蔥伯克霍爾德菌群
洋蔥伯克霍爾德菌群(Burkholderia cepacia Complex�����,Bcc)隸屬于伯克霍爾德菌屬����,該屬共有122個種��,將其中表型近似����、基因型存在差異的菌種進行劃分�,命名為洋蔥伯克霍爾德菌群(Bcc)�,截止至2021年�����,已被分類命名的Bcc成員達到24個種。Bcc作為條件致病菌�,能引起多種醫(yī)院感染�,引起敗血癥����、心內(nèi)膜炎�����、肺炎��、傷口感染和膿腫等�����,且該菌在患者和患者之間具有較強的傳播能力��,由于其多重耐藥特性����,治療相當困難。
? ? ? 洋蔥伯克霍爾德菌(Burkholderia cepacia�,B.c)于1947年由康奈爾大學(xué)教授從洋蔥根部分離出來�����,可引起洋蔥根莖腐爛�,最初被命名為洋蔥假單胞菌��。隨著分子生物學(xué)鑒定技術(shù)的發(fā)展�����,1992 年該菌被重新分類命名為洋蔥伯克霍爾德菌,洋蔥伯克霍爾德菌(B.c)是一種廣泛存在于水、土壤��、植物和人體中的革蘭氏陰性桿菌,革蘭氏染色結(jié)果見圖1���。

圖1?洋蔥伯克霍爾德菌CMCC(B)23005染色鏡檢圖片
三����、洋蔥伯克霍爾德菌群的檢驗
? ?在各領(lǐng)域現(xiàn)行的標準體系中,洋蔥伯克霍爾德菌/群的檢驗方法有3 種:SN/T 4684—2016《進出口化妝品中洋蔥伯克霍爾德菌檢驗方法》���、SN/T 4485—2016《進出口口腔清潔類產(chǎn)品中洋蔥伯克霍爾德菌檢驗方法》及USP<60>Microbiological examination of nonsterileproducts-test for?Burkholderia cepacia?complex����。
? ? ? 2022年11月中國藥典首次頒布了《洋蔥伯克霍爾德菌群檢查法草案公示稿(第一次)洋蔥伯克霍爾德菌群檢查法》��,文本中首次出現(xiàn)了洋蔥伯克霍爾德菌群選擇性瓊脂培養(yǎng)基(BCCSA)���。本方法中選擇具有代表性的3株Bcc菌株作為培養(yǎng)基適用性試驗和檢查方法適用性試驗的試驗菌�����,分別為洋蔥伯克霍爾德菌(Burkholderia cepacia)〔CMCC(B)23005〕、 新洋蔥伯克霍爾德菌(Burkholderia cenocepacia)〔CMCC(B)23006〕���、神秘伯克霍爾德菌(Burkholderia aenigmatica)〔CMCC(B)23010〕�。
檢驗流程方法如圖2:

圖2?洋蔥伯克霍爾德菌群檢驗流程
四��、洋蔥伯克霍爾德菌群選擇性瓊脂培養(yǎng)基(BCCSA)
? 胰蛋白胨、酵母提取物提供微生物生長所需的氮源�;多數(shù)Bcc成員都可利用蔗糖和丙酮酸鈉�����,所以將上述兩種物質(zhì)作為碳源����;氯化鈉作為滲透壓穩(wěn)定劑�;結(jié)晶紫可抑制革蘭氏陽性菌及部分真菌生長����;三種抗生素的添加可有效抑制大部分革蘭氏陽性菌及部分革蘭氏陰性菌生長���,由于Bcc的廣譜耐藥性�����,其可在該培養(yǎng)基上生長良好�。BCCSA培養(yǎng)基采用酚紅作為指示劑,根據(jù)其變色范圍(低于6.6呈現(xiàn)黃色)將初始pH調(diào)整為6.2±0.2�,使得空白平皿呈現(xiàn)黃色�����,如圖3所示�����;為了保證在接種Bcc后���,當菌株代謝產(chǎn)生堿性產(chǎn)物時�,培養(yǎng)基的pH能夠快速升高,并體現(xiàn)在其顏色變化上發(fā)揮指示作用�,選擇磷酸二氫鉀作為pH緩沖劑�����;洋蔥伯克霍爾德菌群在BCCSA培養(yǎng)基上菌落形態(tài)為:菌落呈灰白��、灰粉色或土黃(棕)色,周圍培養(yǎng)基由黃色變橘紅或玫紅色����。在TSA上Bcc菌落呈亮淡黃色�,隆起,邊緣整齊至不規(guī)則���。不同洋蔥伯克霍爾德菌在BCCSA和TSA培養(yǎng)基上的菌落形態(tài)見圖4-圖8����。

圖3:洋蔥伯克霍爾德菌群選擇性瓊脂培養(yǎng)基(BCCSA)?空白平皿??

圖4:洋蔥伯克霍爾德菌 Burkholderia cepacia??CMCC(B)23005
圖5:新洋蔥伯克霍爾德菌Burkholderia cenocepacia?CMCC?(B)23006

圖6:神秘伯克霍爾德菌 Burkholderia aenigmatica??CMCC(B)23010

圖7:洋蔥伯克霍爾德菌 Burkholderia cepacia??ATCC 25608

圖8:洋蔥伯克霍爾德菌 Burkholderia cepacia??ATCC 25416
五�����、標準定量菌株
為了方便使用,我公司推出了《中國藥典》(2020版)推薦的三株洋蔥伯克霍爾德菌群定量菌株��。定量菌株操作便捷���,數(shù)量適宜�����,菌量為102-103CFU/支�����。具體操作流程見圖9���。

圖9:定量菌株操作流程
六���、產(chǎn)品信息及列表

洋蔥伯克霍爾德菌群選擇性培養(yǎng)基

洋蔥伯克霍爾德菌群定量菌株

七��、參考文獻
1.?王似錦�,余萌���,王杠杠�����,等. 非無菌藥品中不可接受微生物的控制與風(fēng)險評估[J].中國藥事����,2020.34(9):1028-1039.
2.?馬英英�,王似錦��,馬仕洪���,等. 非無菌藥品中不可接受微生物的檢驗控制策略[J].中國藥事���,2023.37(4):389-395.
3.?紉秋. 水中魅影——洋蔥伯克霍爾德菌[J].食有新意��,22-23.
4.?李皇��,張耀平���,梁林慧. 洋蔥伯克霍爾德菌在幾種腸道選擇性培養(yǎng)基上的生長比較及對VITEK 鑒定的影響[J].廣西醫(yī)科大學(xué)學(xué)報,2009.26(1):98-100.
5.?羅俊,王娜娜����,莊意瓊,?等. 一株化妝品中洋蔥伯克霍爾德菌生長特性研究[J].科技創(chuàng)新與應(yīng)用��,2022.(35):7-11.
6.?王似錦,余萌,楊美琴,周發(fā)友,馬仕洪,胡昌勤.凝膠劑中1株洋蔥伯克霍爾德菌的分離���、鑒定與生長特性研究[J].藥物分析雜志,2019,39(09):1617-1624.
7.?楊學(xué)芳,蔡蓉.蒲地藍消炎口服液及純化水中洋蔥伯克霍爾德菌檢查方法的研究[J].中國中醫(yī)藥現(xiàn)代遠程教育,2022,20(01):143-145.
8.?余萌,王似錦,曹蕊,馬仕洪.洋蔥伯克霍爾德菌群(Bcc)的選擇和分離培養(yǎng)基研究[J].中國藥事,2022,36(07):746-757.
9.?USP42 [S]. 2019:7695-7701,7687-6788.
10.?中華人民共和國藥典:四部[S]. 2020:170-171.
11.?Parenteral Drug Association. Technical Report No. 67?Exclusion of Objectionable Microorganisms from Nonsterile?Pharmaceuticals, Medical Devices, and Cosmetics[R].USA:Parenteral Drug Association���,2014:1-63.